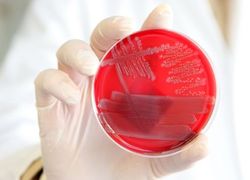
Normal_759

BERLIJN (ANP) - De snelheid waarmee de gevaarlijke darmbacterie EHEC zich in Duitsland verspreidt, neemt aanmerkelijk af. Dat heeft minister van Volksgezondheid Daniel Bahr woensdag gezegd tegen de publieke omroep ARD.
,,Er zullen nog nieuwe gevallen bijkomen en we moeten voorbereid zijn op meer sterfgevallen, maar het aantal nieuwe infecties is aanmerkelijk aan het dalen'', zei Bahr. ,,Ik kan nog niet het sein veilig geven, maar na analyse van de nieuwste gegevens hebben we een redelijke aanleiding tot hoop.''









